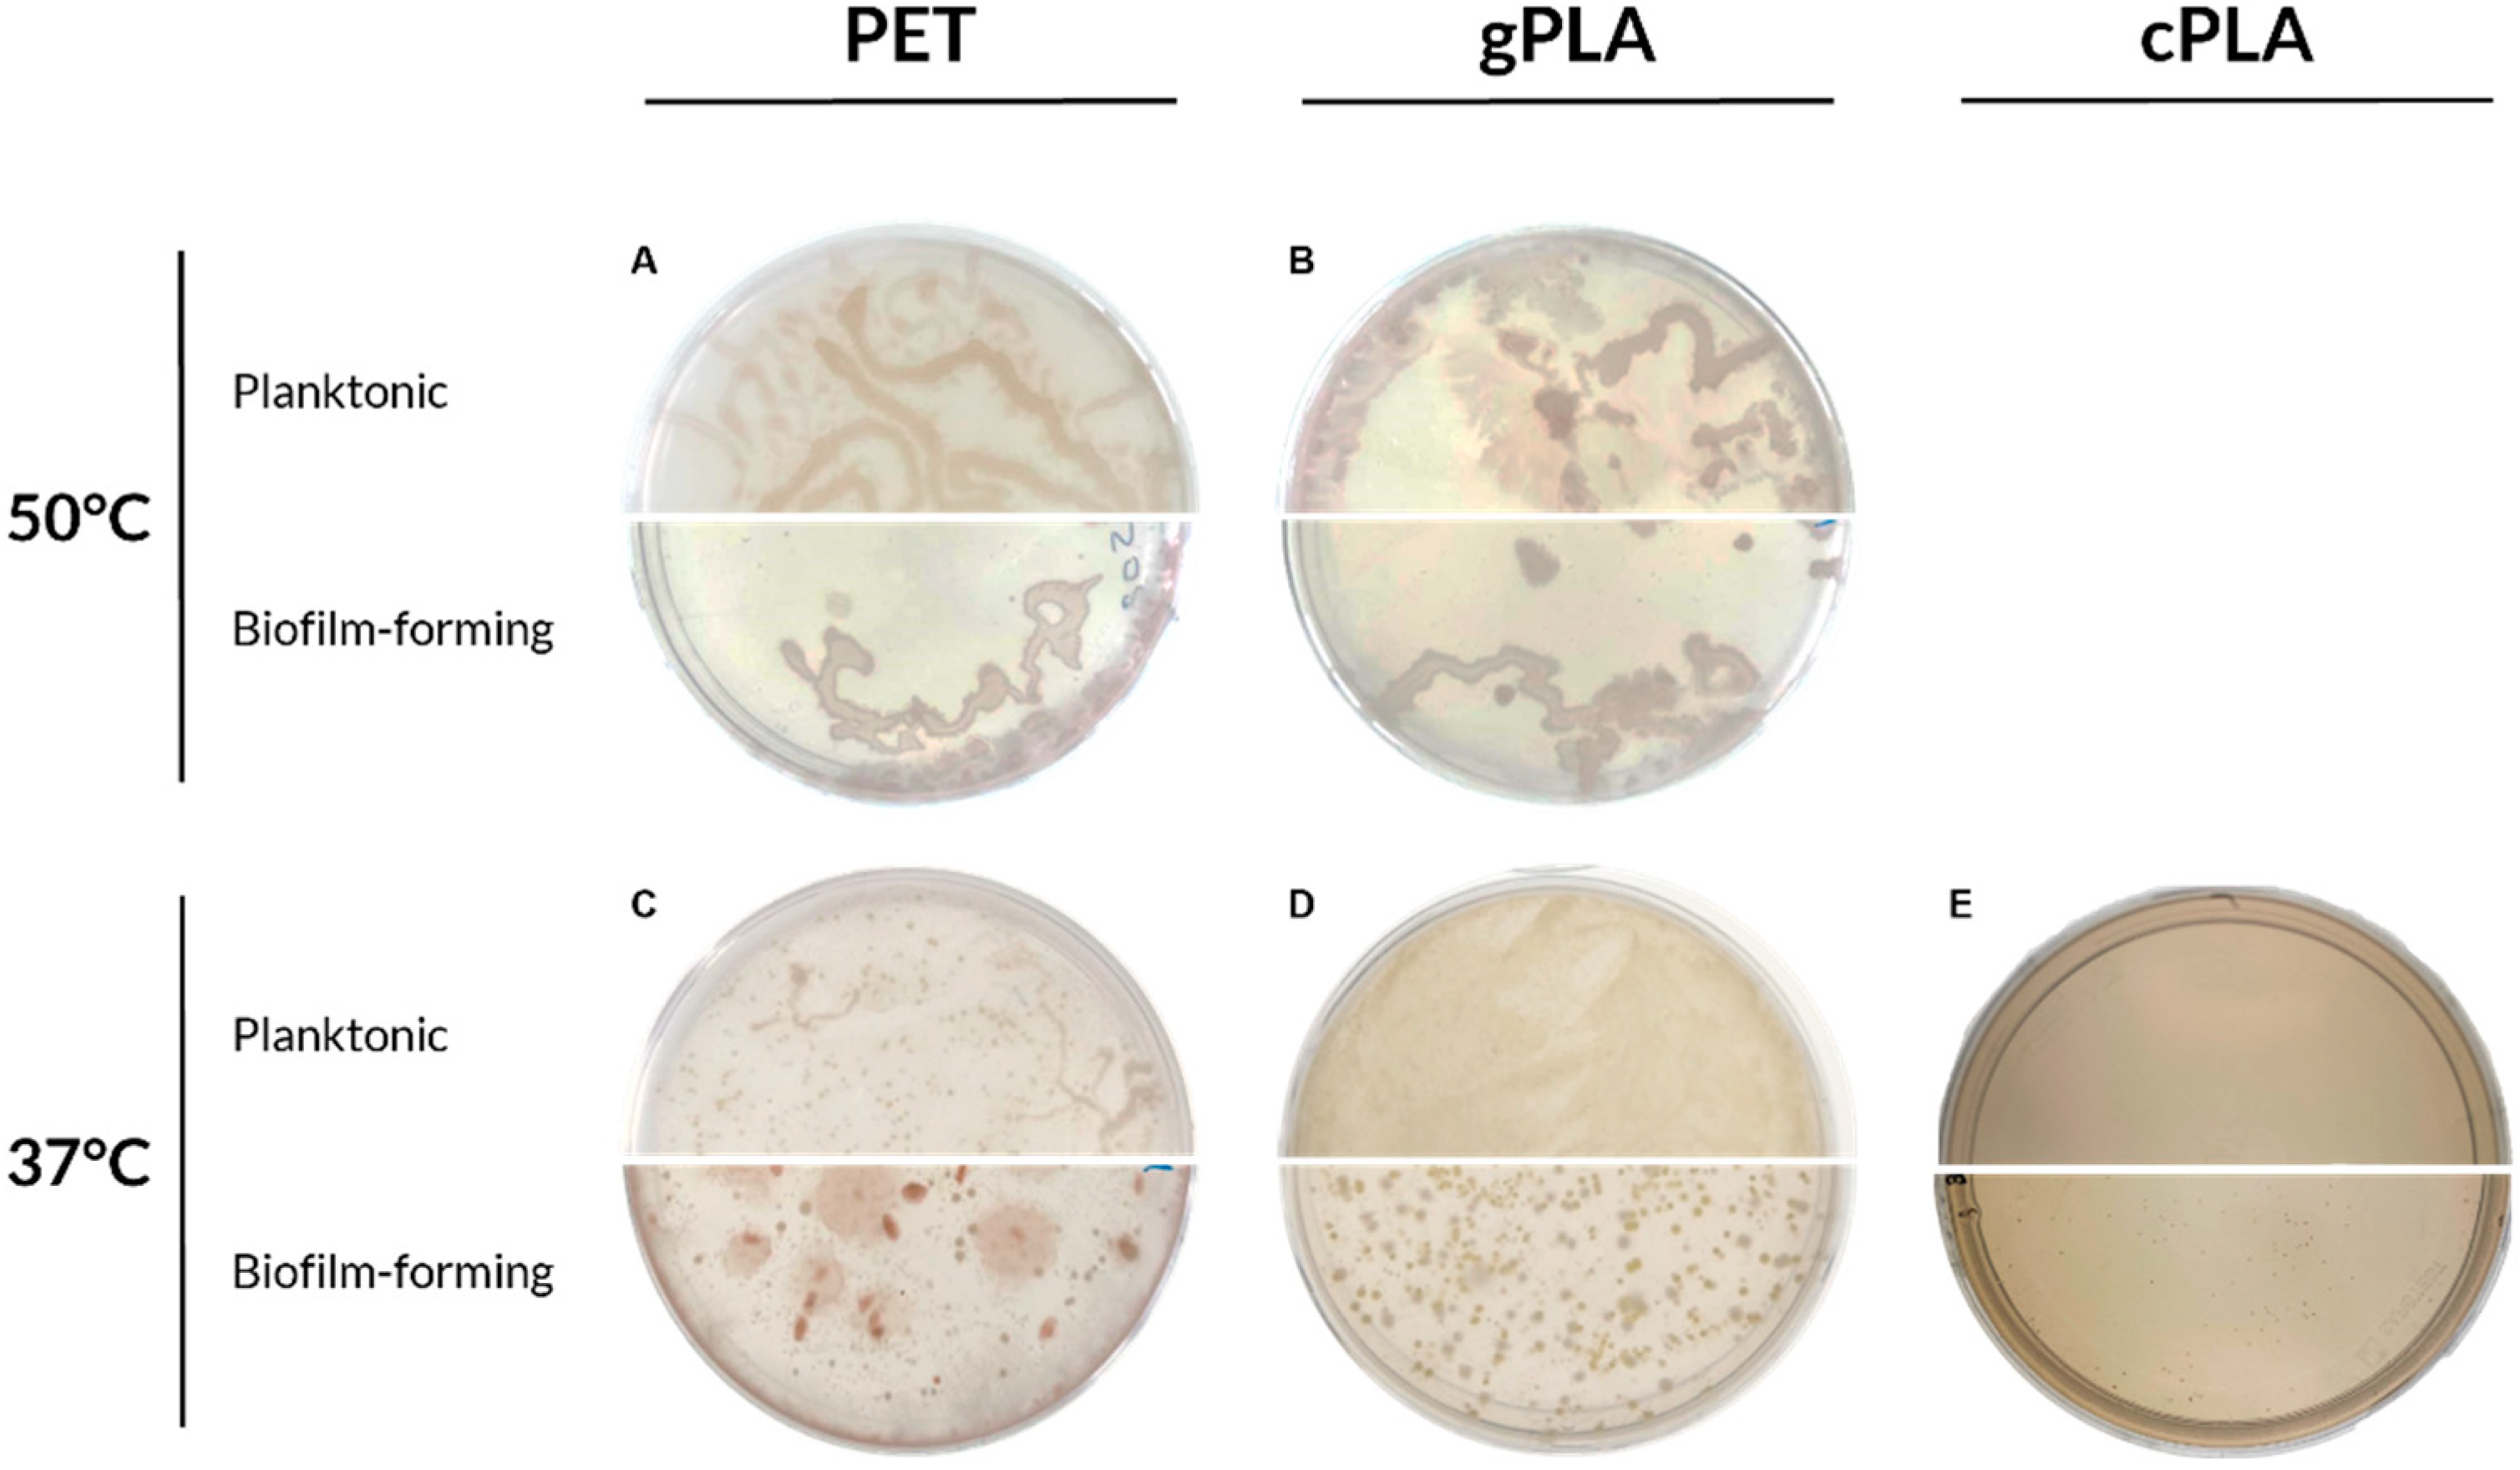
Ijms 25 12747 g002

Plastic-Degrading Microbial Consortia from a Wastewater Treatment Plant
Abstract
1. Introduction
2. Results
2.1. Enrichment and Isolation of Microbial Consortia
2.2. Characterization of Plastic Polymers
2.3. Microbiomes and Sequence Analysis
3. Discussion
4. Conclusions
5. Materials and Methods
5.1. Activated Sludge Characterization
5.2. Media and Chemicals
5.3. Plastic-Containing Agar Plates
5.4. Enrichment Cultures
5.4.1. Microbial Biomass Measurements
5.4.2. NMR and GPC Analyses
5.4.3. Elemental Analysis
5.4.4. Thermal and InfraRed Analyses
5.5. Microbial Consortia Analysis
5.5.1. DNA Extraction and Quality Analyses
5.5.2. Sequence Analyses
Supplementary Materials
Author Contributions
Funding
Institutional Review Board Statement
Informed Consent Statement
Data Availability Statement
Acknowledgments
Conflicts of Interest
References
- Global Plastics Outlook Economic Drivers, Environmental Impacts and Policy Options; 9789264654945; OECD: Paris, France, 2022.
- Plastics Europe. Plastics—The Fast Facts 2023; Plastics Europe: Frankfurt, Germany, 2023. [Google Scholar]
- Borrelle, S.B.; Ringma, J.; Law, K.L.; Monnahan, C.C.; Lebreton, L.; McGivern, A.; Murphy, E.; Jambeck, J.; Leonard, G.H.; Hilleary, M.A.; et al. Predicted growth in plastic waste exceeds efforts to mitigate plastic pollution. Science 2020, 1518, 1515–1518. [Google Scholar] [CrossRef] [PubMed]
- Kumar, M.; Xiong, X.; He, M.; Tsang, D.C.; Gupta, J.; Khan, E.; Harrad, S.; Hou, D.; Ok, Y.S.; Bolan, N.S. Microplastics as pollutants in agricultural soils. Environ. Pollut. 2020, 265, 114980. [Google Scholar] [CrossRef] [PubMed]
- Pico, Y.; Alfarhan, A.; Barcelo, D. Nano- and microplastic analysis: Focus on their occurrence in freshwater ecosystems and remediation technologies. TrAC Trends Anal. Chem. 2019, 113, 409–425. [Google Scholar] [CrossRef]
- Wong, J.K.H.; Lee, K.K.; Tang, K.H.D.; Yap, P.-S. Microplastics in the freshwater and terrestrial environments: Prevalence, fates, impacts and sustainable solutions. Sci. Total Environ. 2020, 719, 137512. [Google Scholar] [CrossRef] [PubMed]
- Frias, J.; Nash, R. Microplastics: Finding a consensus on the definition. Mar. Pollut. Bull. 2019, 138, 145–147. [Google Scholar] [CrossRef]
- Zhang, K.; Hamidian, A.H.; Tubić, A.; Zhang, Y.; Fang, J.K.; Wu, C.; Lam, P.K. Understanding plastic degradation and microplastic formation in the environment: A review. Environ. Pollut. 2021, 274, 116554. [Google Scholar] [CrossRef]
- Rafa, N.; Ahmed, B.; Zohora, F.; Bakya, J.; Ahmed, S.; Ahmed, S.F.; Mofijur, M.; Chowdhury, A.A.; Almomani, F. Microplastics as carriers of toxic pollutants: Source, transport, and toxicological effects. Environ. Pollut. 2024, 343, 123190. [Google Scholar] [CrossRef]
- Teuten, E.L.; Saquing, J.M.; Knappe, D.R.; Barlaz, M.A.; Jonsson, S.; Björn, A.; Rowland, S.J.; Thompson, R.C.; Galloway, T.S.; Yamashita, R.; et al. Transport and release of chemicals from plastics to the environment and to wildlife. Philos. Trans. R. Soc. B Biol. Sci. 2009, 364, 2027–2045. [Google Scholar] [CrossRef]
- Chamas, A.; Moon, H.; Zheng, J.; Qiu, Y.; Tabassum, T.; Jang, J.H.; Abu-Omar, M.; Scott, S.L.; Suh, S. Degradation Rates of Plastics in the Environment. ACS Sustain. Chem. Eng. 2020, 8, 3494–3511. [Google Scholar] [CrossRef]
- Corcoran, P.L.; Sciences, E. An anthropogenic marker horizon in the future rock record. GSA Today 2013, 6, 4–8. [Google Scholar] [CrossRef]
- Haram, L.E.; Carlton, J.T.; Ruiz, G.M.; Maximenko, N.A. A Plasticene Lexicon. Mar. Pollut. Bull. 2020, 150, 110714. [Google Scholar] [CrossRef] [PubMed]
- Global Plastics Outlook Policy Scenarios to 2060; 9789264973640; OECD: Paris, France, 2022.
- Zhu, B.; Wang, D.; Wei, N. Enzyme discovery and engineering for sustainable plastic recycling. Trends Biotechnol. 2022, 40, 22–37. [Google Scholar] [CrossRef] [PubMed]
- García-Depraect, O.; Lebrero, R.; Rodriguez-Vega, S.; Bordel, S.; Santos-Beneit, F.; Martínez-Mendoza, L.J.; Börner, R.A.; Börner, T.; Muñoz, R. Biodegradation of bioplastics under aerobic and anaerobic aqueous conditions: Kinetics, carbon fate and particle size effect. Bioresour. Technol. 2022, 344, 126265. [Google Scholar] [CrossRef] [PubMed]
- Zampolli, J.; Mangiagalli, M.; Vezzini, D.; Lasagni, M.; Ami, D.; Natalello, A.; Arrigoni, F.; Bertini, L.; Lotti, M.; Di Gennaro, P. Oxidative degradation of polyethylene by two novel laccase-like multicopper oxidases from Rhodococcus opacus R7. Environ. Technol. Innov. 2023, 32, 103273. [Google Scholar] [CrossRef]
- Tournier, V.; Duquesne, S.; Guillamot, F.; Cramail, H.; Taton, D.; Marty, A.; André, I. Enzymes’ Power for Plastics Degradation. Chem. Rev. 2023, 123, 5612–5701. [Google Scholar] [CrossRef]
- Wei, R.; Tiso, T.; Bertling, J.; O’connor, K.; Blank, L.M.; Bornscheuer, U.T. Possibilities and limitations of biotechnological plastic degradation and recycling. Nat. Catal. 2020, 3, 867–871. [Google Scholar] [CrossRef]
- Buchholz, P.C.F.; Feuerriegel, G.; Zhang, H.; Perez-Garcia, P.; Nover, L.; Chow, J.; Streit, W.R.; Pleiss, J. Plastics degradation by hydrolytic enzymes: Theplastics-activeenzymes database—PAZy. Proteins Struct. Funct. Bioinform. 2022, 90, 1443–1456. [Google Scholar] [CrossRef]
- Sulaiman, S.; Yamato, S.; Kanaya, E.; Kim, J.-J.; Koga, Y.; Takano, K.; Kanaya, S. Isolation of a Novel Cutinase Homolog with Polyethylene Terephthalate-Degrading Activity from Leaf-Branch Compost by Using a Metagenomic Approach. Appl. Environ. Microbiol. 2012, 78, 1556–1562. [Google Scholar] [CrossRef]
- Williams, D.F. Enzymic Hydrolysis of Polylactic Acid. Eng. Med. 1981, 10, 5–7. [Google Scholar] [CrossRef]
- Tokiwa, Y.; Konno, M.; Nishida, H. Isolation of Silk Degrading Microorganisms and Its Poly(l-lactide) Degradability. Chem. Lett. 1999, 28, 355–356. [Google Scholar] [CrossRef]
- Kawai, F.; Nakadai, K.; Nishioka, E.; Nakajima, H.; Ohara, H.; Masaki, K.; Iefuji, H. Different enantioselectivity of two types of poly(lactic acid) depolymerases toward poly(l-lactic acid) and poly(d-lactic acid). Polym. Degrad. Stab. 2011, 96, 1342–1348. [Google Scholar] [CrossRef]
- Ali, S.S.; Elsamahy, T.; Al-Tohamy, R.; Zhu, D.; Mahmoud, Y.A.-G.; Koutra, E.; Metwally, M.A.; Kornaros, M.; Sun, J. Plastic wastes biodegradation: Mechanisms, challenges and future prospects. Sci. Total Environ. 2021, 780, 146590. [Google Scholar] [CrossRef] [PubMed]
- Rillig, M.C.; Kim, S.W.; Zhu, Y.-G. The soil plastisphere. Nat. Rev. Microbiol. 2024, 22, 64–74. [Google Scholar] [CrossRef] [PubMed]
- Amaral-Zettler, L.A.; Zettler, E.R.; Mincer, T.J. Ecology of the plastisphere. Nat. Rev. Microbiol. 2020, 18, 139–151. [Google Scholar] [CrossRef]
- Giangeri, G.; Morlino, M.S.; De Bernardini, N.; Ji, M.; Bosaro, M.; Pirillo, V.; Antoniali, P.; Molla, G.; Raga, R.; Treu, L.; et al. Preliminary investigation of microorganisms potentially involved in microplastics degradation using an integrated metagenomic and biochemical approach. Sci. Total Environ. 2022, 843, 157017. [Google Scholar] [CrossRef]
- Kim, M.Y.; Kim, C.; Moon, J.; Heo, J.; Jung, S.P.; Kim, J.R. Polymer Film-Based Screening and Isolation of Polylactic Acid (PLA)-Degrading Microorganisms. J. Microbiol. Biotechnol. 2017, 27, 342–349. [Google Scholar] [CrossRef]
- Jiménez, D.J.; Chaparro, D.; Sierra, F.; Custer, G.F.; Feuerriegel, G.; Chuvochina, M.; Diaz-Garcia, L.; Mendes, L.W.; Santiago, Y.P.O.; Rubiano-Labrador, C.; et al. Engineering the mangrove soil microbiome for selection of polyethylene terephthalate-transforming bacterial consortia. Trends Biotechnol. 2024, Online now. [Google Scholar] [CrossRef]
- Ali, S.; Rehman, A.; Hussain, S.Z.; Bukhari, D.A. Characterization of plastic degrading bacteria isolated from sewage wastewater. Saudi J. Biol. Sci. 2023, 30, 103628. [Google Scholar] [CrossRef] [PubMed]
- Yoshida, S.; Hiraga, K.; Takehana, T.; Taniguchi, I.; Yamaji, H.; Maeda, Y.; Toyohara, K.; Miyamoto, K.; Kimura, Y.; Oda, K. A bacterium that degrades and assimilates poly(ethylene terephthalate). Science 2016, 351, 1196–1199. [Google Scholar] [CrossRef]
- Salinas, J.; Carpena, V.; Martínez-Gallardo, M.R.; Segado, M.; Estrella-González, M.J.; Toribio, A.J.; Jurado, M.M.; López-González, J.A.; Suárez-Estrella, F.; López, M.J. Development of plastic-degrading microbial consortia by induced selection in microcosms. Front. Microbiol. 2023, 14, 1143769. [Google Scholar] [CrossRef]
- Magni, S.; Binelli, A.; Pittura, L.; Giacomo, C.; Della, C.; Carla, C.; Regoli, F. The fate of microplastics in an Italian Wastewater Treatment Plant. Sci. Total Environ. 2019, 652, 602–610. [Google Scholar] [CrossRef] [PubMed]
- Ju, F.; Guo, F.; Ye, L.; Xia, Y.; Zhang, T. Metagenomic analysis on seasonal microbial variations of activated sludge from a full-scale wastewater treatment plant over 4 years. Environ. Microbiol. Rep. 2014, 6, 80–89. [Google Scholar] [CrossRef] [PubMed]
- Gambarini, V.; Pantos, O.; Joanne, M.K.; Weaver, L.; Kim, M.H.; Lear, G. Phylogenetic Distribution of Plastic-Degrading Microorganisms. mSystems 2021, 6, 10–1128. [Google Scholar] [CrossRef] [PubMed]
- Gambarini, V.; Pantos, O.; Kingsbury, J.M.; Weaver, L.; Handley, K.M.; Lear, G. PlasticDB: A database of microorganisms and proteins linked to plastic biodegradation. Database 2022, 2022, baac008. [Google Scholar] [CrossRef]
- Auta, H.; Emenike, C.; Fauziah, S. Screening of Bacillus strains isolated from mangrove ecosystems in Peninsular Malaysia for microplastic degradation. Environ. Pollut. 2017, 231, 1552–1559. [Google Scholar] [CrossRef]
- Zhou, N.; Carroll, A.L.; Aryal, O.; Teitel, K.P.; Wilson, R.S.; Zhang, L.; Kapoor, A.; Castaneda, E.; Guss, A.M.; Waldbauer, J.R.; et al. Mechanisms of Polyethylene Terephthalate Pellet Fragmentation into Nanoplastics and Assimilable Carbons by Wastewater Comamonas. Environ. Sci. Technol. 2024, 58, 19338–19352. [Google Scholar] [CrossRef]
- Torena, P.; Alvarez-Cuenca, M.; Reza, M. Biodegradation of polyethylene terephthalate microplastics by bacterial communities from activated sludge. Can. J. Chem. Eng. 2021, 99, S69–S82. [Google Scholar] [CrossRef]
- Kawai, F. The Current State of Research on PET Hydrolyzing Enzymes Available for Biorecycling. Catalysts 2021, 11, 206. [Google Scholar] [CrossRef]
- Nachod, B.; Keller, E.; Hassanein, A.; Lansing, S. Assessment of Petroleum-Based Plastic and Bioplastics Degradation Using Anaerobic Digestion. Sustainability 2021, 13, 13295. [Google Scholar] [CrossRef]
- Apinya, T.; Sombatsompop, N.; Prapagdee, B. Selection of a Pseudonocardia sp. RM423 that accelerates the biodegradation of poly(lactic) acid in submerged cultures and in soil microcosms. Int. Biodeterior. Biodegradation 2015, 99, 23–30. [Google Scholar] [CrossRef]
- Samantaray, P.K.; Little, A.; Wemyss, A.M.; Iacovidou, E.; Wan, C. Design and Control of Compostability in Synthetic Biopolyesters. ACS Sustain. Chem. Eng. 2021, 9, 9151–9164. [Google Scholar] [CrossRef]
- Salinas, J.; Martínez-Gallardo, M.R.; Jurado, M.M.; Suárez-Estrella, F.; López-González, J.A.; Estrella-González, M.J.; Toribio, A.J.; Carpena-Istán, V.; Barbani, N.; Cappello, M.; et al. Microbial consortia for multi-plastic waste biodegradation: Selection and validation. Environ. Technol. Innov. 2024, 36, 103887. [Google Scholar] [CrossRef]
- Song, Y.; PG, R.; Elsworth, D. Synergistic Effects of Urease-Producing and Plastic-Degrading Bacteria to Mitigate Microplastic Generation at the Source in Landfills; 4808683; SSRN: Atlanta, GA, USA, 2024. [Google Scholar]
- Gregory, G.J.; Wang, C.; Sadula, S.; Koval, S.; Lobo, R.F.; Vlachos, D.G.; Papoutsakis, E.T. Polyethylene Valorization by Combined Chemical Catalysis with Bioconversion by Plastic-Enriched Microbial Consortia. ACS Sustain. Chem. Eng. 2023, 11, 3494–3505. [Google Scholar] [CrossRef]
- Schneier, A.; Melaugh, G.; Sadler, J.C. Engineered plastic-associated bacteria for biodegradation and bioremediation. Biotechnol. Environ. 2024, 1, 7. [Google Scholar] [CrossRef] [PubMed]
- Mayumi, D.; Akutsu-Shigeno, Y.; Uchiyama, H.; Nomura, N.; Nakajima-Kambe, T. Identification and characterization of novel poly(dl-lactic acid) depolymerases from metagenome. Appl. Microbiol. Biotechnol. 2008, 79, 743–750. [Google Scholar] [CrossRef]
- Kawai, F.; Oda, M.; Tamashiro, T.; Waku, T.; Tanaka, N.; Yamamoto, M.; Mizushima, H.; Miyakawa, T.; Tanokura, M. A novel Ca2+-activated, thermostabilized polyesterase capable of hydrolyzing polyethylene terephthalate from Saccharomonospora viridis AHK190. Appl. Microbiol. Biotechnol. 2014, 98, 10053–10064. [Google Scholar] [CrossRef]
- Tchigvintsev, A.; Tran, H.; Popovic, A.; Kovacic, F.; Brown, G.; Flick, R.; Hajighasemi, M.; Egorova, O.; Somody, J.C.; Tchigvintsev, D.; et al. The environment shapes microbial enzymes: Five cold-active and salt-resistant carboxylesterases from marine metagenomes. Appl. Microbiol. Biotechnol. 2015, 99, 2165–2178. [Google Scholar] [CrossRef]
- Blázquez-Sánchez, P.; Engelberger, F.; Cifuentes-Anticevic, J.; Sonnendecker, C.; Griñén, A.; Reyes, J.; Díez, B.; Guixé, V.; Richter, P.K.; Zimmermann, W.; et al. Antarctic Polyester Hydrolases Degrade Aliphatic and Aromatic Polyesters at Moderate Temperatures. Appl. Environ. Microbiol. 2022, 88, e0184221. [Google Scholar] [CrossRef] [PubMed]
- Mohanan, N.; Wong, M.C.-H.; Budisa, N.; Levin, D.B. Polymer-Degrading Enzymes of Pseudomonas chloroaphis PA23 Display Broad Substrate Preferences. Int. J. Mol. Sci. 2023, 24, 4501. [Google Scholar] [CrossRef]
- Bertanza, G.; Pedrazzani, R.; Grande, M.D.; Papa, M.; Zambarda, V.; Montani, C.; Steimberg, N.; Mazzoleni, G.; Di Lorenzo, D. Effect of biological and chemical oxidation on the removal of estrogenic compounds (NP and BPA) from wastewater: An integrated assessment procedure. Water Res. 2011, 45, 2473–2484. [Google Scholar] [CrossRef]
- American Public Health Association; American Water Works Association; Water Environment Federation. Standard Methods for the Examination of Water and Wastewater, 20th ed.; APHA-AWWA-WEF: Washington, DC, USA, 1998. (In English) [Google Scholar]
- Charnock, C. A simple and novel method for the production of polyethylene terephthalate containing agar plates for the growth and detection of bacteria able to hydrolyze this plastic. J. Microbiol. Methods 2021, 185, 106222. [Google Scholar] [CrossRef] [PubMed]
- Metcalf, R.; White, H.L.; Ormsby, M.J.; Oliver, D.M.; Quilliam, R.S. From wastewater discharge to the beach: Survival of human pathogens bound to microplastics during transfer through the freshwater-marine continuum. Environ. Pollut. 2023, 319, 120955. [Google Scholar] [CrossRef] [PubMed]
- Chivian, D.; Jungbluth, S.P.; Dehal, P.S.; Wood-Charlson, E.M.; Canon, R.S.; Allen, B.H.; Clark, M.M.; Gu, T.; Land, M.L.; Price, G.A.; et al. Metagenome-assembled genome extraction and analysis from microbiomes using KBase. Nat. Protoc. 2023, 18, 208–238. [Google Scholar] [CrossRef] [PubMed]
- Bolger, A.M.; Lohse, M.; Usadel, B. Trimmomatic: A flexible trimmer for Illumina sequence data. Bioinformatics 2014, 30, 2114–2120. [Google Scholar] [CrossRef]
- Menzel, P.; Ng, K.L.; Krogh, A. Fast and sensitive taxonomic classification for metagenomics with Kaiju. Nat. Commun. 2016, 7, 11257. [Google Scholar] [CrossRef]
- Nurk, S.; Meleshko, D.; Korobeynikov, A.; Pevzner, P.A. metaSPAdes: A new versatile metagenomic assembler. Genome Res. 2017, 27, 824–834. [Google Scholar] [CrossRef]
- Hyatt, D.; Chen, G.-L.; Locascio, P.F.; Land, M.L.; Larimer, F.W.; Hauser, L.J. Prodigal: Prokaryotic gene recognition and translation initiation site identification. BMC Bioinform. 2010, 11, 119. [Google Scholar] [CrossRef]
- Eddy, S.R. Accelerated Profile HMM Searches. PLoS Comput. Biol. 2011, 7, e1002195. [Google Scholar] [CrossRef]
- Katoh, K.; Standley, D.M. MAFFT Multiple Sequence Alignment Software Version 7: Improvements in Performance and Usability. Mol. Biol. Evol. 2013, 30, 772–780. [Google Scholar] [CrossRef]
- Guicherd, M.; Ben Khaled, M.; Guéroult, M.; Nomme, J.; Dalibey, M.; Grimaud, F.; Alvarez, P.; Kamionka, E.; Gavalda, S.; Noël, M.; et al. An engineered enzyme embedded into PLA to make self-biodegradable plastic. Nature 2024, 631, 884–890. [Google Scholar] [CrossRef]

| Entry | Sample | Mn(NMR) b (g mol−1) | Mn(GPC) c (g mol−1) | Mw(GPC) c (g mol−1) | D c | C/H d |
|---|---|---|---|---|---|---|
| 1 | cPLABLK | n.d. | 95,000 | 177,400 | 1.9 | 0.68 |
| 2 | cPLAAC-37°C | n.d. | 66,100 | 124,500 | 1.9 | 0.67 |
| 3 | cPLAEC-37°C | 1300 | 1100 | 5000 | 4.5 | 0.69 |
| 4 | gPLABLK | n.d. | 118,100 | 215,200 | 1.8 | 0.77 |
| 5 | gPLAAC-37°C | 55,300 | 49,400 | 117,000 | 2.4 | 0.76 |
| 6 | gPLAEC-37°C | 950 | 600 | 1000 | 1.7 | 0.70 |
| 7 | gPLAAC-50°C | 1000 | 600 | 900 | 1.5 | 0.74 |
| 8 | gPLAEC-50°C | 800 | n.d. | n.d. | n.d. | 0.71 |
| Sample Name | n° ORFs | Relative PLA Hydrolase Content with Respect to AS INOCULUM | |
|---|---|---|---|
| PLA Hydrolase Annotated | Total | ||
| AS inoculum | 39 | 186,302 | 1 |
| PET-37 °C | 10 | 29,560 | 1.62 |
| PET-50 °C | 8 | 4269 | 8.95 |
| cPLA-37 °C | 3 | 22,820 | 0.63 |
| gPLA-37 °C | 8 | 40,131 | 0.95 |
| gPLA-50 °C | 8 | 4255 | 8.98 |
| Activated Sludge | |
|---|---|
| TS (mg/L) | 8.68 ± 0.09 |
| TVS (mg/L) | 5.85 ± 0.09 |
| Ash (mg/L) | 2.84 ± 0.10 |
| Sample Name | Polymer Type | Polymer Concentration | Incubation Temperature |
|---|---|---|---|
| PET-37 °C | Post-consumer PET bottles | 10% (w/v) | 37 °C |
| gPLA-37 °C | Virgin PLA granules | 33% (w/v) | 37 °C |
| cPLA-37 °C | Post-consumer PLA cups | 10% (w/v) | 37 °C |
| PET-50 °C | Post-consumer PET bottles | 10% (w/v) | 50 °C |
| gPLA-50 °C | Virgin PLA granules | 33% (w/v) | 50 °C |
Disclaimer/Publisher’s Note: The statements, opinions and data contained in all publications are solely those of the individual author(s) and contributor(s) and not of MDPI and/or the editor(s). MDPI and/or the editor(s) disclaim responsibility for any injury to people or property resulting from any ideas, methods, instructions or products referred to in the content. |
© 2024 by the authors. Licensee MDPI, Basel, Switzerland. This article is an open access article distributed under the terms and conditions of the Creative Commons Attribution (CC BY) license (https://creativecommons.org/licenses/by/4.0/).
Share and Cite
Salini, A.; Zuliani, L.; Gonnelli, P.M.; Orlando, M.; Odoardo, A.; Ragno, D.; Aulitto, M.; Zaccone, C.; Fusco, S. Plastic-Degrading Microbial Consortia from a Wastewater Treatment Plant. Int. J. Mol. Sci. 2024, 25, 12747. https://doi.org/10.3390/ijms252312747
Salini A, Zuliani L, Gonnelli PM, Orlando M, Odoardo A, Ragno D, Aulitto M, Zaccone C, Fusco S. Plastic-Degrading Microbial Consortia from a Wastewater Treatment Plant. International Journal of Molecular Sciences. 2024; 25(23):12747. https://doi.org/10.3390/ijms252312747
Chicago/Turabian StyleSalini, Andrea, Luca Zuliani, Paolo Matteo Gonnelli, Marco Orlando, Andrea Odoardo, Daniele Ragno, Martina Aulitto, Claudio Zaccone, and Salvatore Fusco. 2024. "Plastic-Degrading Microbial Consortia from a Wastewater Treatment Plant" International Journal of Molecular Sciences 25, no. 23: 12747. https://doi.org/10.3390/ijms252312747
APA StyleSalini, A., Zuliani, L., Gonnelli, P. M., Orlando, M., Odoardo, A., Ragno, D., Aulitto, M., Zaccone, C., & Fusco, S. (2024). Plastic-Degrading Microbial Consortia from a Wastewater Treatment Plant. International Journal of Molecular Sciences, 25(23), 12747. https://doi.org/10.3390/ijms252312747









